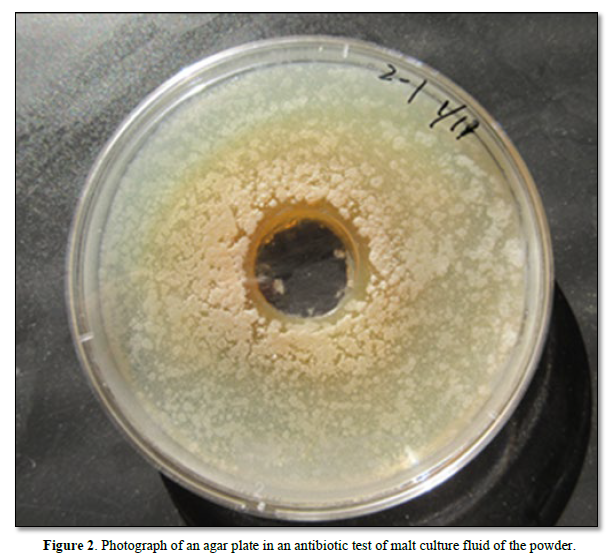
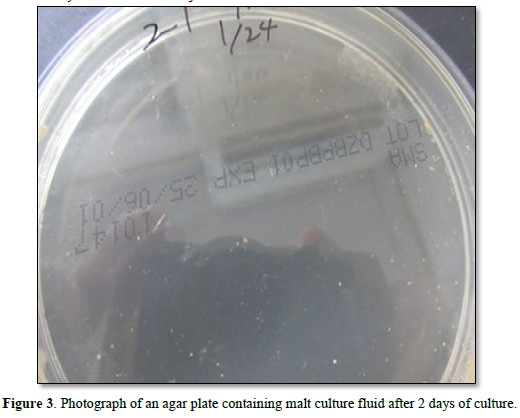
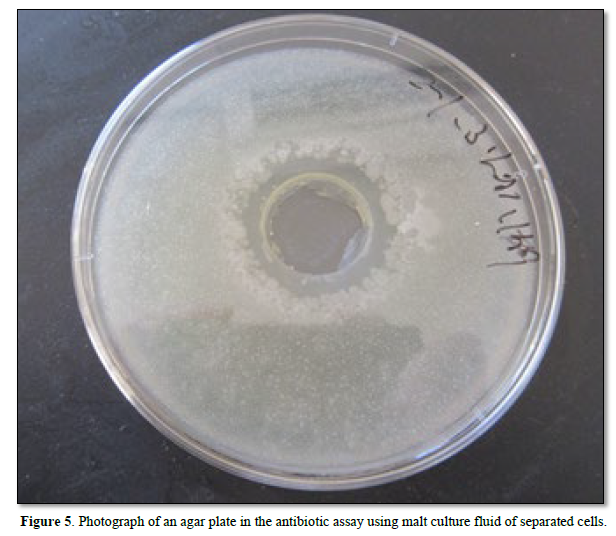

846
Views & Citations10
Likes & Shares
Keywords: DNA (Streptomyces) crown cells, Sphingosine-DNA, Antibiotic crown-Strept-yeast cells, monolaurin, Egg white powder
Synthetic DNA crown cells were synthesized using four common commercial compounds: sphingosine (Sph), DNA, adenosine, and monolaurin. The cells were prepared by culturing within egg white. In previous studies, various types of objects, as well as cell proliferation, were observed when monolaurin-treated synthetic DNA (E. coli/human placenta/Ascidian/Streptomyces) crown cells were cultivated with or without egg white on agar plates [4-7].
Also, it was demonstrated that antibiotic-producing cells could be isolated through stimulation with egg white and monolaurin from beer, and were produced in co-cultures of DNA crown cells and yeast [8]. It was suggested that these cells could be separated after stimulation with these materials. Moreover, it was found that the cells could be separated from objects that formed in agar plate cultures of synthetic DNA (Streptomyces) crown cells and monolaurin and/egg white [9].
In this study, it was examined whether antibiotic producing cells were separated from culture fluids of the powder in the use as a powder of egg white enclosing DNA (Streptomyces) crown cells and yeast. Here, it was described that antibiotic-producing cells were separated from culture fluids of the powder and were referred to as antibiotic crown strep-yeast cells-p.
MATERIALS AND METHODS
Materials
DNA (Streptomyces) crown cells, prepared as described previously [10-12] were used in this study. In addition, the materials used were the same as those employed in previous studies [10-12]: Sph (Tokyo Kasei, Japan), DNA (from Streptomyces), adenosine (Sigma-Aldrich; Wako, Japan), monolaurin (Tokyo Kasei), and adenosine-monolaurin (A-M), a compound synthesized from a mixture of adenosine and monolaurin. Monolaurin solutions were prepared to a final concentration of 0.1 M in distilled water. Agar plates were prepared using standard agar medium (SMA) (AS ONE, Japan).
Materials used to test antibiotics
Malt, Black Rock (Brewing Instructions, New Zealand) was obtained from Advanced Brewing (Tokyo, Japan). Dry Ale Yeast (Safale S-04; Formentis Bergy) were obtained from a beer kit (Aubercraft, Okazaki, Japan) and prepared in accordance with the manufacturer’s instructions.
Potato dextrose agar (PDA) was obtained from Kyodo Nyugiou (Tokyo, Japan) and Bacillus subtilis was obtained from Daikokuya (Nagoya, Japan).
Methods
Preparation of synthetic DNA (Streptomyces) crown cells
The methods used to produce DNA (Streptomyces) crown cells are the same as those described previously [12], Briefly, Sph (10 mM) and DNA (1.7 µg/µL) were combined and A-M solution was added. After the mixture was incubated, monolaurin solution was added. Then, approximately 0.3 mL of the mixture was added to the egg white and incubated for 7 days at 37°C. Then, egg white was recovered and used as DNA (Streptomyces) crown cells. Preparation of powder:
- First, 3 ml of yeast suspension (10 mg/mL) was mixed with 3 mL of egg white.
- The mixture was then incubated for 5 hours at 37°C
- About 25 mL of fresh egg white was added to the mixture
- The mixture was poured into two Petri dishes and dried for 1-2 days at 37°C
- Dried materials were collected by grinding with a mortar and pestle to form a powder
- The powder (Figure 1) was stored at room temperature before use

Preparation of sample used for antibiotic assay
A small amount of powder (Approximately 30 mg) was added to 5.0 mL of malt and incubated for 3-7 days at room temperature (about 20°C). The resulting culture medium was used as the sample for testing.
Preparation of plates for assaying antibiotic production
The antibody assay was carried out using the agar well method, as described previously (8). The test bacteria were mixed with 200 mL agar medium and dispensed into Petri dishes. A well measuring about 2 cm in diameter was produced in each plate. The test fluid (about 400 mL) was dispensed into each plate, and the plate was incubated for 18 h at 37°C. After incubation, the zone of inhibition was observed.
Separation of antibiotic-producing cells (Separation from antibiotic-containing malt)
The liquid sample (200 mL) used in the antibiotic assay was poured onto an agar plate and was incubated for 2 days at 37°C.
About 1.5 ml of egg white was then poured onto the plate and the plate was reversed.
The plates were then incubated for 2 days at 37°C.
Malt cultures of separated objects
Samples were selected by picking and incubated with 5.0 ml malt at room temperature for 3-7 days. The resulting culture solution was used for antibiotic assays.
Observations
Objects on plates were observed directly with the naked eye.
RESULTS
Figure 2 shows a photograph of an agar plate in an antibiotic test of malt culture fluid of the powder (Egg white powder enclosed DNA (Streptomyses) crown cells and Yeast). A clear zone, which had a diameter of 8.0 cm, was observed in the center of the Petri dish.
Figure 3 shows a photograph of an agar plate containing malt culture fluid after 2 days of culture. No objects were visible to the naked eye on the Petri dish.
Figure 4 shows a photograph of an agar plate after the addition of egg white.

Objects (antibiotic producing cells) visible to the naked eye were observed on the Petri dish.
Figure 5 shows a photograph of an agar plate in the antibiotic assay using malt culture fluid of separated cells in Figure 4 a clear zone was observed.
Previously, the author demonstrated that antibiotic was produced in co-cultures of yeast and DNA (Streptomyces) crown cells [12-15], and also that antibiotic-producing cells were separated from beer after stimulation with egg white or monolaurin [8]. It was previously suggested that these cells were separated after stimulation with these materials. It was also reported that, in experiments using agar plates cultures of synthetic DNA crown cells stimulated with egg white or monolaurin, various objects were observed [4-7].
In the present experiment, DNA (Streptomyces) crown cells were mixed with yeast and made a powder with egg white. Here, it was examined whether antibiotic producing cells could be separated from the culture fluids of this powder. When the powder was inoculated with the malt, antibiotic was found in the culture fluid. Also, antibiotic-producing cells could be separated from the fluid after stimulation with egg white without monolaurin.
However, it was unclear whether the use as a powder had any effect on the production of antibiotic-producing cells. On the other hand, the present methods to separate antibiotic producing cells in the use of powder was straightforward in operation and the powder could be stored at room temperature.
Furthermore, it remained uncertain whether the cells currently present or the antibiotics were identical to those previously separated, specifically the cells (antibiotic crown Strept-yeast cells-b, c) and the antibiotics (crown antibiotic 1, 2) [8,9]. Moreover, it was unclear whether the antibiotic production observed in this study is unique to DNA (Streptomyces) crown cells or whether it can be produced by other kinds of DNA crown cells.
In addition, as described previously [8], no experiments have been conducted on the origin of the cells and the characteristics of the antibiotic and there may be possibility which was selected in non-science. For the first time, this study describes the separation of antibiotic-producing cells, using DNA crown cells prepared as a powder.
Future studies will examine whether new antibiotic-producing cells can be produced and separated using the powder-based method described in this study.
As described previously Inooka S [8], the author named the cells antibiotic crown-Strept-yeast cells-p., i.e., a combination of DNA (Streptomyces) crown cells with yeast, and p for powder (the culture source). It is possible that different antibiotics can be produced. Thus, the cells were named based on the fact that the antibiotic was produced using crown cells (i.e., antibiotic crown), and since the antibiotic in the present experiments represents the third finding, it is named “crown antibiotic-3”.
- Inooka S (2012) Preparation and cultivation of artificial cells. App Cell Biol 25: 13-18.
- Inooka S (2016) Preparation of Artificial Cells Using Eggs with Sphingosine-DNA. J Chem Eng Process Technol l7: 277.
- Inooka S (2016) Aggregation of sphingosine-DNA and cell construction using components from egg white. Integr Mol Med 3(6): 1-5.
- Inooka S (2024) Synthesis and Microscopic Appearance of Thalus-like Objects tin Synthetic DNA ( coli) Crown Cells Created Using Monolaurin and Egg white. Open Access J Reprod Sys Sexual Disorder 3: 2.
- Inooka S (2024) Double Cell-Like Objects Created from synthetic DNA (Human Placenta) Crown Cells using Monolaurin. Am J Med Clin Sci 9(2): 1-3.
- Inooka S (2024) Morning glory-and Dandelion-like Objects Created in Agar Cultures of Synthetic DNA (Ascidian) Crown Cells with Monolaurin and Egg white. Ann Rev Res 10(8): 1-6.
- Inooka S (2024) Cell ring-like objects created in agar cultures of synthetic DNA (Streptomyces) cells with monolaurin. Clin Cardiol Cardiovasc Interv 7(7): 1-8.
- Inooka S (2025) Separation of Antibiotic-Producing Cells from Beer Produced in Co-cultures of DNA (Streptomyces) Crown Cells with Yeast. Ann Rev Res 12(3): 5558399.
- Inooka S. Separation of antibiotic producing cells from the agar cultures of synthetic DNA (Streptomyces) crown cells with monolaurin and egg white. J Biotechnol Biores.
- Inooka S (2017) Biochemical and Systematic Preparation of Artificial Cells. Glob J Res Eng 17: 11C.
- Inooka S (2017) Systematic Preparation of Artificial Cells (DNA Crown Cells). J Chem Eng Process Technol 8: 327.
- Inooka S (2019) Preparation of Generated DNA (Streptomyces Griseus) Crown Cells (Artificial Cells) and Antibiotic Production in Its’ Co-Cultures wuth Yeast (Beer). Curr Trends Biotechnol Microbiol 1(2): 2019.
- Inooka S (2019) Antibiotic Production in Co-Cultures of DNA (Streptomyces) Crown Cells (Artificial Cells) and Yeast (Beer). Chem Pharm Res 1(2): 1-4.
- Inooka S (2020) Large scale antibiotic production in co-cultures of DNA (Streptomyces griseous) crown cells (artificial cells) and beer yeast. Appl Cell Biol Jpn 33: 49-58.
- Inooka S (2020) On the mechanism of Antibiotic Production in Co-Cultures of Generated DNA (Streptomyces Griseous) crown Cells (Artificial Cells) with Yeast (Beer). Novel Res Sci 5(1): 1-5.






